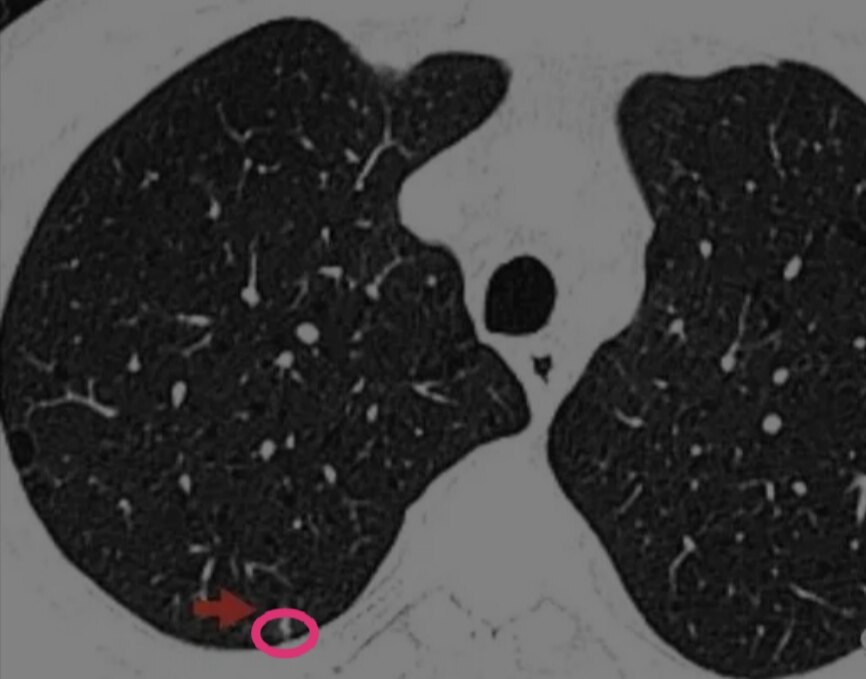
Screenshot_20210107_053311.jpg

患者、吸烟男性,有肺气肿,胸部CT体检发现的胸膜下实性微小结节(≤5mm),绝大多数为陈旧性病灶。多无需处理,观察即可。但是有一种人群,胸膜下实性微小结节需要关注,那就是——男性、吸烟、肺气肿患者。
看下这个结节。男性,重度吸烟史,肺气肿背景,CT发现右上肺后段胸膜下,实性5mm的结节。
该图片可能引起不适
继续查看
右下肺后段肺部微小实性结节
该图片可能引起不适
继续查看

右下肺后段肺部微小实性结节
该图片可能引起不适
继续查看

右下肺后段肺部微小实性结节
此为实性结节,5mm,没有毛刺征、胸膜凹陷征及血管弯曲等任何肿瘤的特征性表现。单凭这个CT,任何一个医生或者人工智能AI,都可能会认为这个结节良性可能大,无法确认这个结节是肺癌。
这个时候,就需要通过患者的临床特点和连续动态胸部CT检查结果:肺部结节发生发展趋势来判断肺结节良恶性了。
首先,男性、吸烟、肺气肿背景,是肺实性结节为恶性的危险因素,也是肺磨玻璃结节生长的危险因素。因此这个患者的肺结节需要重视。
马上再来看一下这个患者肺结节4个月之前的胸部CT图像:
该图片可能引起不适
继续查看

可以看到,这个肺部实性结节四个月之内有增大趋势。这个时候就更需要警惕了。那么,是否可以就此确定这个肺部微小实性结节就是肺癌吗?还是不行,因为右上肺尖后段为结核好发部位,结核也可能短期内增大。
这里有个需要注意的点:4个月短期增大的肺部实性结节,要么是恶性程度很高的肺癌,低分化神经内分泌癌(或者转移性),要么是炎症性(包括结核)。
那么怎么鉴别肿瘤和结核?
决定性的证据来了:
回看患者5年前(2015年)的胸部CT,该相同位置,表现为一个肺部微小的磨玻璃结节。
该图片可能引起不适
继续查看

这显然不符合肺结核以及其他肺部炎症结节的生长规律,病史上可以排除肺结核和肺部炎症。
至比,我们认为这个肺结节是恶性的可能大,患者接受微创胸腔镜手术切除,术后病理为神经内分泌癌。
这个患者显然是不幸中的大幸,这个结节已经进入快速生长阶段,如果再等半年,很有可能已经转移。
最后,再次建议不要吸烟。